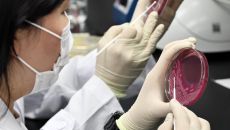

언론사별 뉴스
2026
일
월
화
수
목
금
토
-

‘1주택 장특공 폐지 법안’ 범여권 공동발의
범여권에서 1주택자의 양도소득세 장기보유특별공제(장특공)를 폐지하는 법안이 발의됐다. 16일 정치권에 따르면 진보당 윤종오 의- 7시간전
- 동아일보
-

친명 핵심 김영진, ‘李 최측근’ 김용 출마 반대
더불어민주당 김영진 의원이 이재명 대통령의 최측근인 김용 전 민주연구원 부원장의 재보궐선거 출마에 대해 “국민 눈높이에 맞춰서- 7시간전
- 동아일보
-

소노, 져주기 의혹 SK에 3연승 본때 보였다
‘언더도그’의 상징이었던 프로농구 막내 구단 소노가 창단 첫 4강 플레이오프(PO·5전 3승제) 무대를 밟는다. 정규리그 5위- 7시간전
- 동아일보
-

홍명보호, 美 솔트레이크서 2주간 고지대 훈련
홍명보호가 2026 북중미(미국, 멕시코, 캐나다) 월드컵 본선을 향한 구체적인 로드맵을 확정, 공개했다. 대한축구협회는 16- 7시간전
- 동아일보
-

자율주행 25t 트럭, 6월 중부고속道 달린다
6월부터 자율주행 트럭이 중부고속도로를 달리며 택배를 운반하는 모습을 보게 될 것으로 전망된다. 국토교통부는 국내 자율주행 전- 7시간전
- 동아일보
-

민주평통 수석부의장 강창일, 진실화해위 상임위원 김귀옥
이재명 대통령은 16일 민주평화통일자문회의(민주평통) 수석부의장에 강창일 전 주일 대사를 임명했다. 차관급 정무직인 진실화해를- 7시간전
- 동아일보
-

맥없는 국힘 “그나마 현역 겨룰만”… 의원들 “배지만 뗄라” 몸사려
6·3 지방선거 광역단체장 공천이 종반을 향하는 가운데 지금까지의 공천 결과는 더불어민주당은 ‘현역 물갈이’, 국민의힘은 ‘현- 7시간전
- 동아일보
-

국힘 경기 의원 6명 전원 “도지사 후보 빨리 확정하라”
경기도에 지역구를 둔 국민의힘 의원 전원이 “하루빨리 경기도지사 최종 후보를 확정해 달라”는 결의문을 16일 발표했다. 당이- 7시간전
- 동아일보
-

“중동 상황 극복” 손잡은 여야정
16일 서울 여의도 국회에서 열린 ‘중동 상황 대응·극복을 위한 더불어민주당-국민의힘 원내대표 긴급 점검 회의’에서 참석자들이- 7시간전
- 동아일보
-

李, ‘김부겸 지지’ 홍준표 만난다… 오늘 靑서 오찬
이재명 대통령이 17일 청와대에서 홍준표 전 대구시장(사진)과 비공개 오찬을 가진다. 청와대 관계자는 16일 “여야 통합 차원- 7시간전
- 동아일보
-

총기 든 괴한 맨몸으로 제압한 美고교 교장, 참사 막아
범인은 지난해 이 학교를 졸업한 빅터 리 호킨스(20)로 확인됐다. 호킨스는 경찰에 “(1999년 발생한) 콜럼바인 고교 총기- 7시간전
- 동아일보
-

전쟁 불똥 맞은 美소고기 값, 한우와 차이 4062원→2719원
최근 창고형 대형마트를 찾은 직장인 이모 씨(42)는 미국산 냉장 살치살 원물(손질되지 않은 덩어리)을 구입하려다 깜짝 놀랐다- 7시간전
- 동아일보
-

李, 오늘 ‘호르무즈 통항 화상 정상회의’ 참석… 연대 메시지 낼 듯
이재명 대통령이 17일(현지 시간) 영국과 프랑스 정상 주도로 열리는 호르무즈 해협 안전 통항을 위한 화상 정상회의에 참석한다- 7시간전
- 동아일보
-
기온 상승속 식중독 주의보
16일 경기 수원시 권선구 경기도보건환경연구원에서 연구원들이 식중독균 배양 분리 작업을 하고 있다. 식품의약품안전처의 식중독- 7시간전
- 동아일보
-

李 “국민 생명 지키는 게 국가가 존재하는 이유… 304개의 꿈 잊지 않겠다”
이재명 대통령이 16일 세월호 참사 12주기 기억식에 참석해 “국가가 존재하는 이유는 바로 국민의 생명과 안전을 지키기 위함”- 7시간전
- 동아일보

